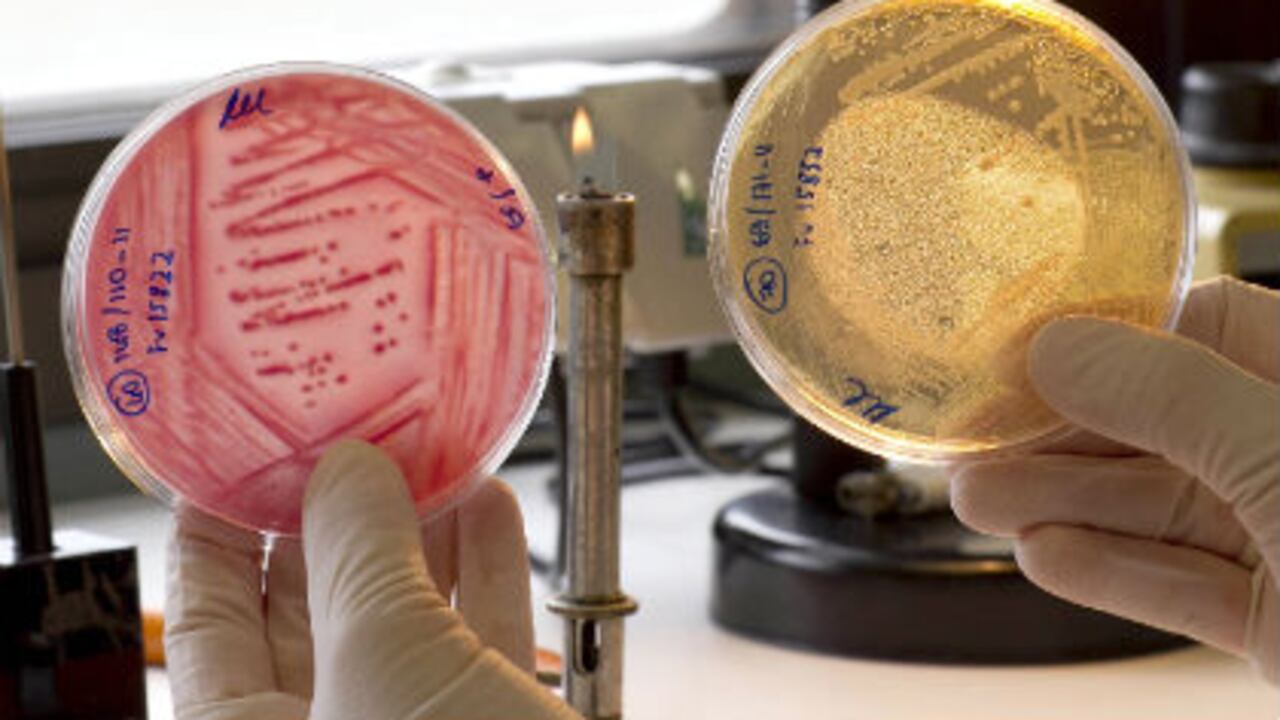
En Alemania, una investigadora analiza muestras de vegetales tras la alerta sanitaria del brote de la bacteria E. coli.

En una circular, el Ministerio de la Protección Social definió las directrices que deben tomar las autoridades sanitarias del país para vigilar y controlar el brote de Escherichia Coli 0104H4 en caso de registrarse en Colombia.
La situación generada por esta bacteria en Europa registra 6.601 casos y también hace presencia en Estados Unidos, Egipto y Canadá.
Solo en Alemania el número de muertos llega a 30. Las autoridades sanitarias del oeste de ese país confirmaron este viernes la presencia directa de esta bacteria en semillas germinadas procedentes de una granja ecológica del estado de baja Sajonia.
Este brote, que la Organización Mundial de la Salud (OMS) califica como “preocupante”, ha generado cientos de casos de Síndrome Hemolítico Urémico (SUH por sus siglas en inglés), que puede producir insuficiencia renal, anemia hemolítica y disminución de plaquetas.
Este síndrome es una complicación de la infección por la Escherichia Coli. Y aunque estas bacterias son inofensivas, existe un grupo, denominado E. coli enterohemorrágica (EHEC), que puede producir unas toxinas que dañan los glóbulos rojos y los riñones.
En Colombia, el Ministerio de la Protección Social ordena a las autoridades sanitarias tomar muestras a las personas cuyo cuadro clínico coincida con la definición del SUH y enviarlas al Laboratorio de Microbiología del Instituto Nacional de Salud.
Según la circular, las autoridades sanitarias deberán notificar de inmediato al sistema de vigilancia en salud pública territorial y nacional los casos de SUH y/o diarrea con sangre, en pacientes con antecedentes o que hayan tenido contacto con personas con historia de viaje a países afectados durante el último mes.
La OMS recomienda intensificar medidas básica de higienes como el lavado de manos después de usar el baño y antes de manipular alimentos, dado que la bacteria puede transmitirse de persona a persona a través de la vía fecal-oral, así como a través de los alimentos, el agua y el contacto directo con animales.
Asimismo, cocinar los alimentos hasta que alcancen una temperatura de 70°C; con esto se logra la destrucción de las bacterias.
Según el Ministerio, se debe consultar al médico de manera inmediata ante la presencia de diarrea sanguinolenta, dolor abdominal y que se tenga el antecedente de viaje a zonas afectadas. El SHU es una complicación que puede producir insuficiencia renal aguda y aparecer después de que la diarrea se haya resuelto.
SALUD
Colombia intensifica vigilancia y control de la E. Coli
El Gobierno emitió las directrices para vigilar y controlar la posible aparición de casos de infección por la E. Coli en el país. Este brote en Alemania deja 30 muertos.
Siga las noticias que marcan la agenda del país en Discover y manténgase al día
9 de junio de 2011 a las 7:00 p. m.